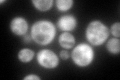
YLL018C
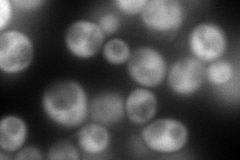
YLL018C
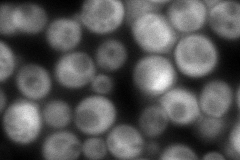
YLL018C
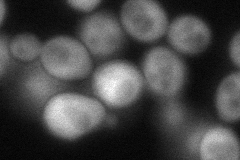
YLL018C
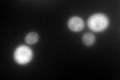
YLL018C
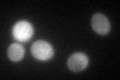
YLL018C

View description
Aspartyl-tRNA synthetase, primarily cytoplasmic; homodimeric enzyme that catalyzes the specific aspartylation of tRNA(Asp); class II aminoacyl tRNA synthetase; binding to its own mRNA may confer autoregulation
Localization:
Intensity:
Fold change:
Significance:
-
C’ GFP library in SD
cytosol209.23 -
N' NOP1pr-GFP in SD
cytosol382.394 -
N' TEF2pr-mCherry in SD

cytosol550.417 -
N' NATIVEpr-GFP in SD
cytosol151.757 -
N' TEF2pr-VC and Cyto-VN in SD
cytosol92.6983 -
C’ GFP library in SD+DTT
cytosol163.970.78No -
C’ GFP library in SD+H2O2

cytosol243.511.16No -
C’ GFP library in Starvation Media
cytosol124.420.59No -
C’ GFP library on the background of Pup2-DaMP

cytosol -
C’ GFP library on the background of CCT mutant

cytosol207.6570.992439No
